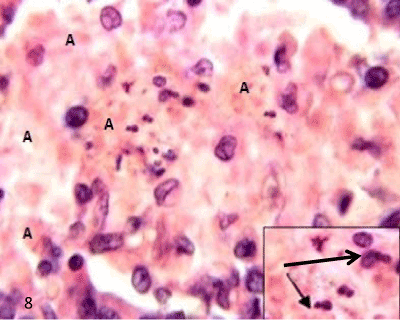

|
| Figure 8: A photomicrograph of rat pancreatic tissue of the diabetic group showing degenerated islet’s cells with nuclear pyknosis and nuclear fragmentation (Inset). Notice the empty spaces leaved after cell degeneration filled with amyloid-like material (A). (Hx&E x1000). |